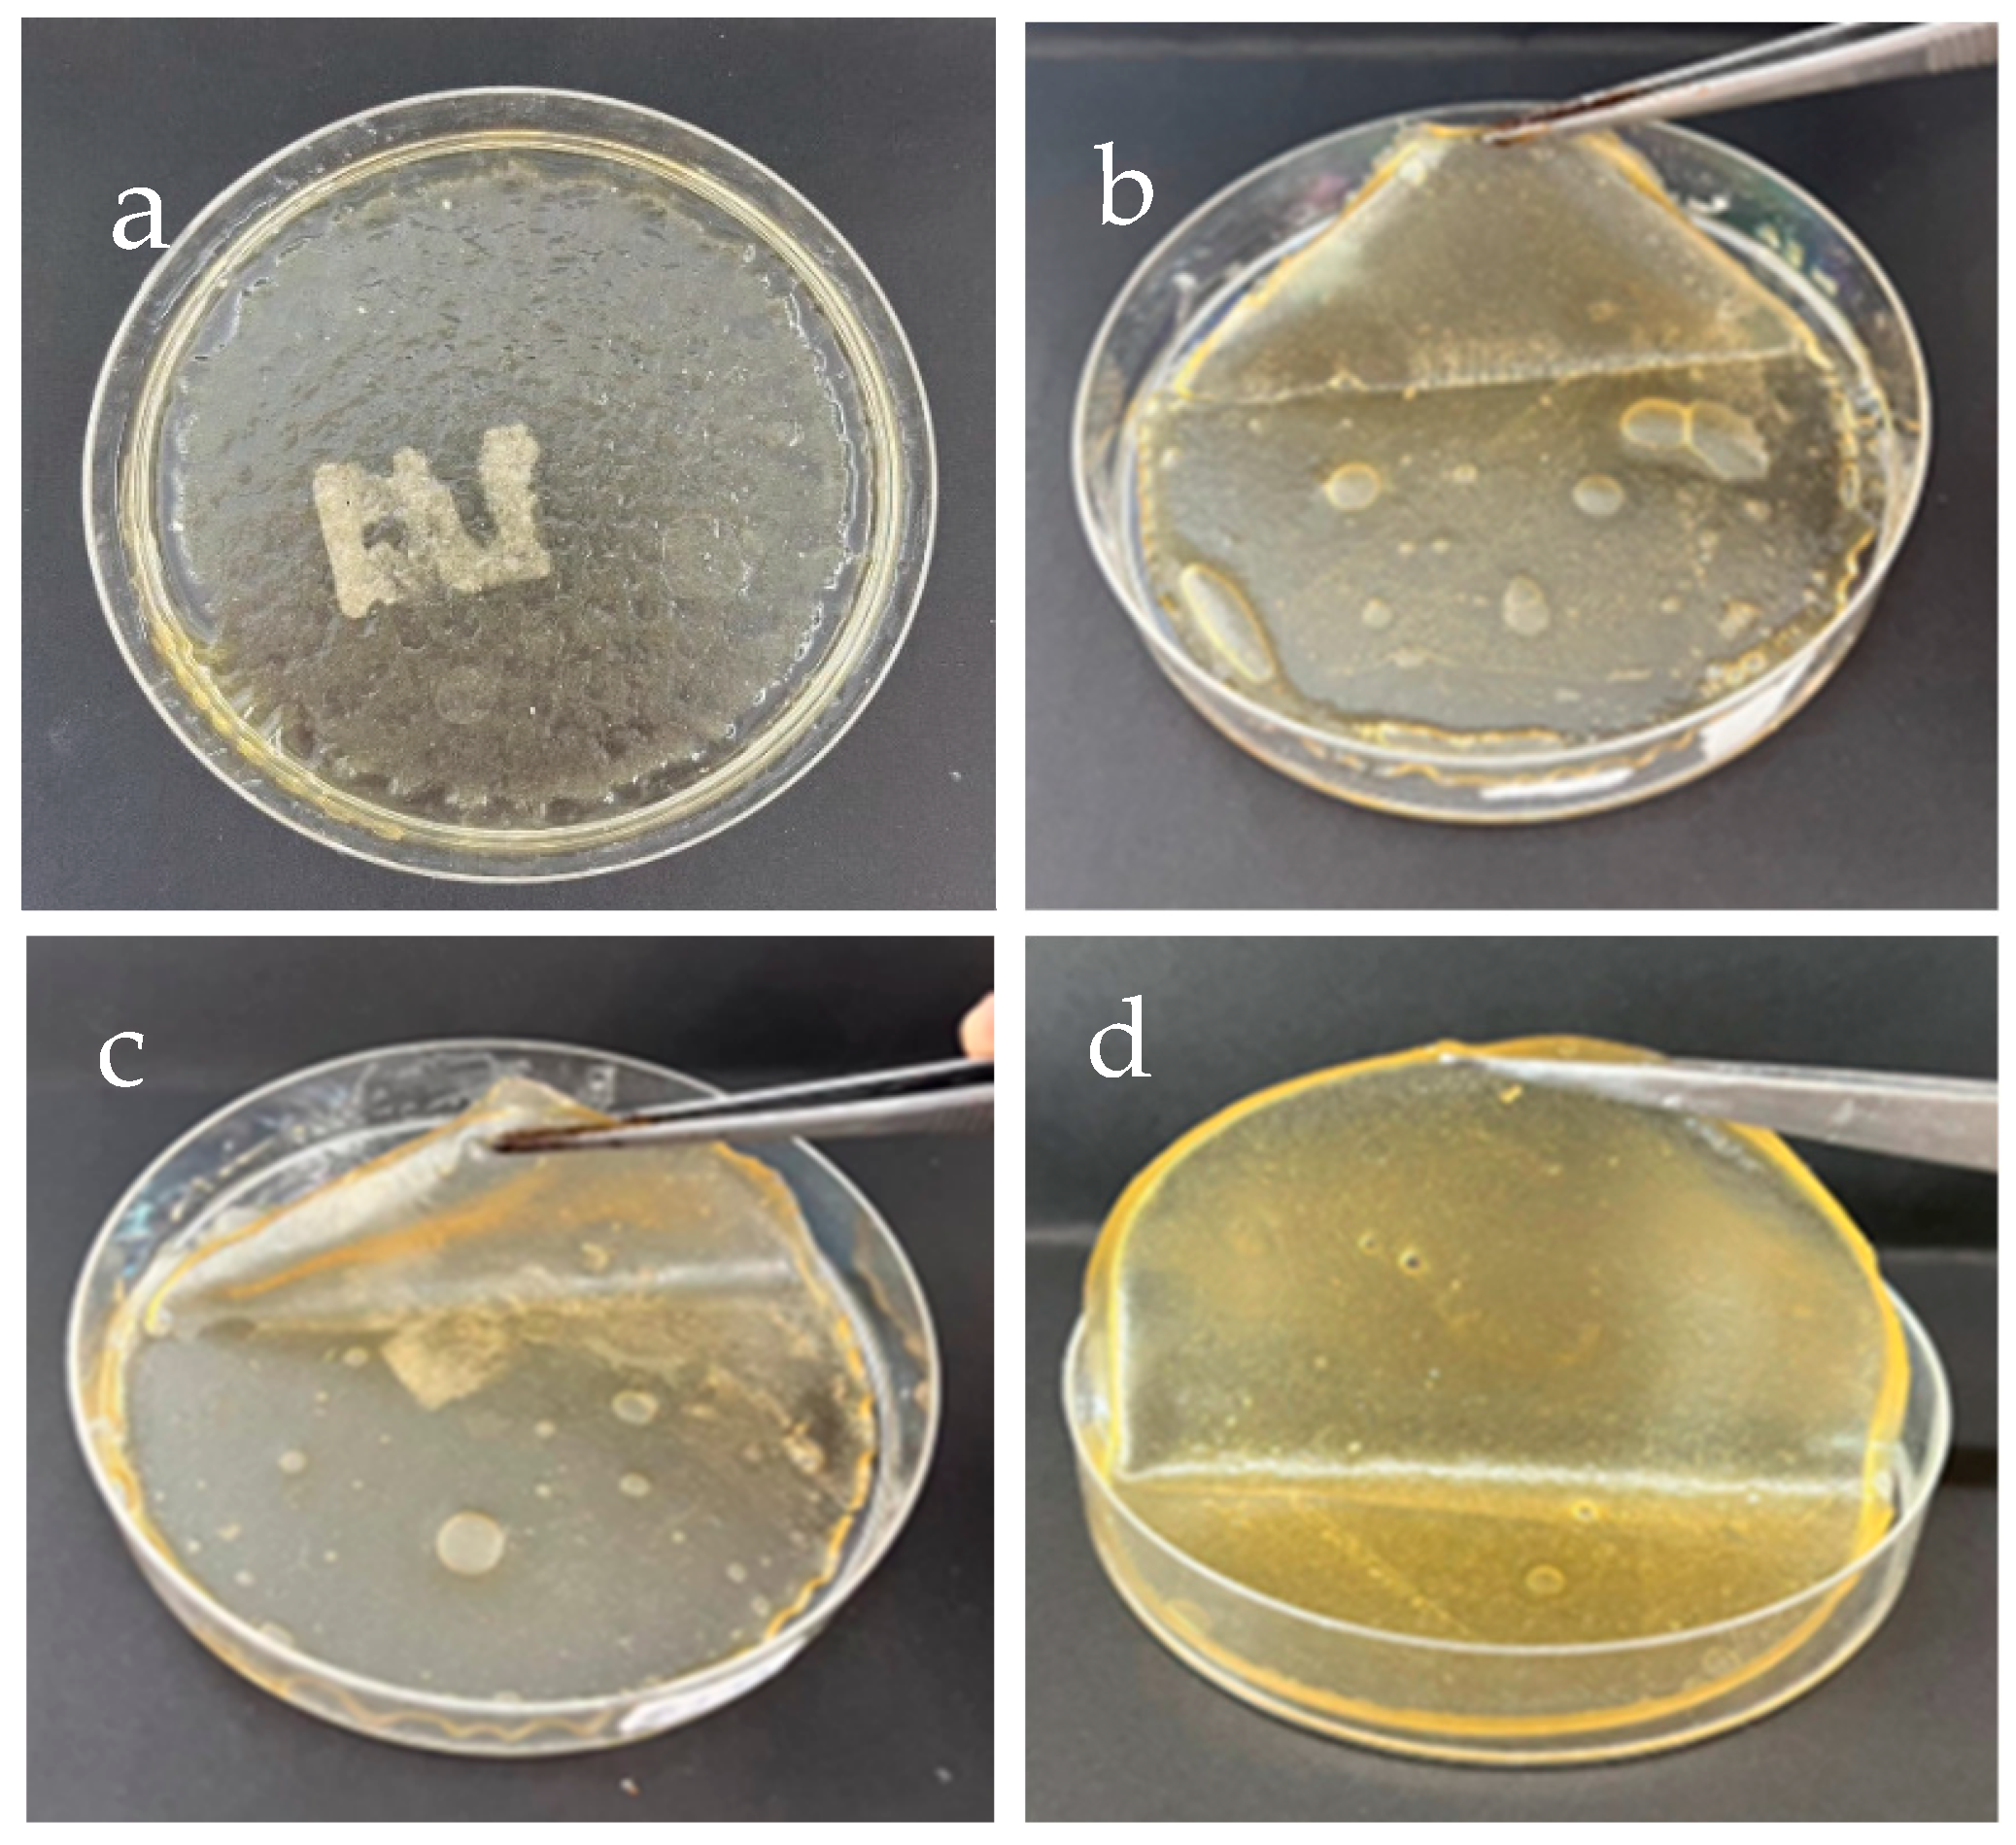
Polymers 17 00425 g001

Effects of Guar Gum and Sodium Benzoate on the Properties and Hydrophilicity of Silk Fibroin Hydrogels
Abstract
:1. Introduction
2. Materials and Methods
2.1. Materials
2.2. Preparation of SF Solution
2.3. Preparation of SF–Based Hydrogels
2.4. Characteristics of SF–Based Hydrogels
2.4.1. Transparency Observation
2.4.2. Analysis of Functional Groups
2.4.3. Thermal Stability
2.4.4. Mechanical Properties
2.4.5. Degradation of SF–based Hydrogels
2.4.6. Hydrophilicity Test
3. Results and Discussion
3.1. Appearance Features
3.1.1. SF–GG–Hydrogels
3.1.2. SF–GG (0.3) Mixed SB Hydrogels
3.2. Transparency and Degradation of the Hydrogel–Based SF
3.3. Mechanical Properties of the Hydrogels
3.4. Clarification of Functional Groups
3.5. Thermal Properties of Hydrogels
4. Conclusions
Author Contributions
Funding
Institutional Review Board Statement
Data Availability Statement
Conflicts of Interest
References
- Corcoran, P.L. Benthic Plastic Debris in Marine and Fresh Water Environments. Environ. Sci. Process Impacts 2015, 17, 1363–1369. [Google Scholar] [CrossRef] [PubMed]
- Liang, X.; Guo, S.; Kuang, X.; Wan, X.; Liu, L.; Zhang, F.; Jiang, G.; Cong, H.; He, H.; Tan, S.C. Recent Advancements and Perspectives on Processable Natural Biopolymers: Cellulose, Chitosan, Eggshell Membrane, and Silk Fibroin. Sci. Bull. 2024, 69, 3444. [Google Scholar] [CrossRef] [PubMed]
- Evode, N.; Qamar, S.A.; Bilal, M.; Barceló, D.; Iqbal, H.M.N. Plastic Waste and Its Management Strategies for Environmental Sustainability. Case Stud. Chem. Environ. Eng. 2021, 4, 100142. [Google Scholar] [CrossRef]
- Haque, S.; Islam, S. Effectiveness of Waste Plastic Bottles as Construction Material in Rohingya Displacement Camps. Cleaner Eng. Technol. 2021, 3, 100110. [Google Scholar] [CrossRef]
- Nayak, S.; Khuntia, S.K. Development and Study of Properties of Moringa oleifera Fruit Fibers/Polyethylene Terephthalate Composites for Packaging Applications. Compos. Commun. 2019, 15, 113–119. [Google Scholar] [CrossRef]
- Shah, S.A.; Sohail, M.; Khan, S.; Minhas, M.U.; Matas, M.de; Sikstone, V.; Hussain, Z.; Abbasi, M.; Kousar, M. Biopolymer-Based Biomaterials for Accelerated Diabetic Wound Healing: A Critical Review. Int. J. Biol. Macromol. 2019, 139, 975–993. [Google Scholar] [CrossRef]
- Rojas-Lema, S.; Nilsson, K.; Trifol, J.; Langton, M.; Gomez-Caturla, J.; Balart, R.; Garcia-Garcia, D.; Morina, R. Faba Bean Protein Films Reinforced with Cellulose Nanocrystals as Edible Food Packaging Material. Food Hydrocoll. 2021, 121, 107019. [Google Scholar] [CrossRef]
- Winnacker, M.; Rieger, B. Recent Progress in Sustainable Polymers Obtained from Cyclic Terpenes: Synthesis, Properties, and Application Potential. Chem. Sus. Chem. 2015, 8, 2455–2471. [Google Scholar] [CrossRef]
- Xie, X.; Liu, L.; Zhang, L.; Lu, A. Strong Cellulose Hydrogel as Underwater Superoleophobic Coating for Efficient Oil/Water Separation. Carbohydr. Polym. 2020, 229, 115467. [Google Scholar] [CrossRef]
- Jonoobi, M.; Oladi, R.; Davoudpour, Y.; Oksman, K.; Dufresne, A.; Hamzeh, Y.; Davoodi, R. Different Preparation Methods and Properties of Nanostructured Cellulose from Various Natural Resources and Residues: A Review. Cellulose 2015, 22, 935–969. [Google Scholar] [CrossRef]
- Lee, K.; Jeon, Y.; Kim, D.; Kwon, G.; Kim, U.-J.; Hong, C.; Choung, J.W.; You, J. Double-Crosslinked Cellulose Nanofiber-Based Bioplastic Films for Practical Applications. Carbohydr. Polym. 2021, 260, 117817. [Google Scholar] [CrossRef] [PubMed]
- Shan, Y.; Li, J.; Nie, M.; Li, D.; Zhang, Y.; Li, Y.; Wang, L.; Liu, L.; Wang, F.; Tong, L.-T. A Comprehensive Review of Starch-Based Technology for Encapsulation of Flavor: From Methods, Materials, and Release Mechanism to Applications. Carbohydr. Polym. 2025, 348, 122816. [Google Scholar] [CrossRef]
- Bialik-Wąs, K.; Kulawik-Pioro, A.; Sienkiewicz, A.; Łętocha, A.; Osinska, J.; Malarz, K.; Mrozek-Wilczkiewicz, A.; Barczewski, M.; Lanoue, A.; Giglioli-Guivarc’h, N.; et al. Design and Development of Multibiocomponent Hybrid Alginate Hydrogels and Lipid Nanodispersion as New Materials for Medical and Cosmetic Applications. Int. J. Biol. Macromol. 2024, 278, 134405. [Google Scholar] [CrossRef] [PubMed]
- Guo, Y.; Qiao, D.; Zhao, S.; Zhang, B.; Xie, F. Advanced Functional Chitosan-Based Nanocomposite Materials for Performance-Demanding Applications. Prog. Polym. Sci. 2024, 157, 101872. [Google Scholar] [CrossRef]
- Sharahi, M.; Bahrami, S.H.; Karimi, A. A Comprehensive Review on Guar Gum and Its Modified Biopolymers: Their Potential Applications in Tissue Engineering. Carbohydr. Polym. 2025, 347, 122739. [Google Scholar] [CrossRef] [PubMed]
- Ali, A.; Bairagi, S.; Ganie, S.A.; Ahmed, S. Polysaccharides and Proteins Based Bionanocomposites as Smart Packaging Materials: From Fabrication to Food Packaging Applications: A Review. Int. J. Biol. Macromol. 2023, 252, 126534. [Google Scholar] [CrossRef] [PubMed]
- Li, R.; Guo, Y.; Dong, A.; Yang, X. Protein-Based Emulsion Gels as Materials for Delivery of Bioactive Substances: Formation, Structures, Applications and Challenges. Food Hydrocoll. 2023, 144, 108921. [Google Scholar] [CrossRef]
- Wang, X.; Liu, Z.; Liu, X.; Ma, W.; Li, L.; Wang, Y. Protein-Based Grafting Modification in the Food Industry: Technology, Applications and Prospects. Trends Food Sci. Technol. 2024, 153, 104751. [Google Scholar] [CrossRef]
- Zamani, B.; Svanström, M.; Peters, G.; Rydberg, T. A Carbon Footprint of Textile Recycling: A Case Study in Sweden. J. Ind. Ecol. 2015, 19, 676–687. [Google Scholar] [CrossRef]
- Altman, G.H.; Diaz, F.; Calabro, C.T.J.; Horan, R.L.; Chen, J.; Lu, H.; Richmond, J.; Kaplan, D.L. Silk- Based Biomaterials. Biomaterials 2003, 24, 401–416. [Google Scholar] [CrossRef]
- Zhang, Y.Q. Applications of Natural Silk Protein Sericin in Biomaterials. Biotechnol. Adv. 2002, 20, 91–100. [Google Scholar] [CrossRef]
- Lamoolphak, W.; De-Eknamkul, W.; Shotipruk, A. Hydrothermal Production and Characterization of Protein and Amino Acids from Silk Waste. Bioresour. Technol. 2008, 99, 7678–7685. [Google Scholar] [CrossRef]
- Liu, H.; Wei, J.; Zheng, L.J.; Zhao, Y.P. Extraction and Characterization of Silk Fibroin from Waste Silk. Adv. Mater. Res. 2013, 788, 174–177. [Google Scholar] [CrossRef]
- Liu, J.; Sun, H.; Peng, Y.; Chen, L.; Xu, W.; Shao, R. Preparation and Characterization of Natural Silk Fibroin Hydrogel for Protein Drug Delivery. Molecules 2022, 27, 3418. [Google Scholar] [CrossRef]
- Koyyada, A.; Orsu, P. Natural Gum Polysaccharides as Efficient Tissue Engineering and Drug Delivery Biopolymers. J. Drug Deliv. Sci. Technol. 2021, 63, 102431. [Google Scholar] [CrossRef]
- Tudu, M.; Samanta, A. Natural Polysaccharides: Chemical Properties and Application in Pharmaceutical Formulations. Eur. Polym. J. 2022, 184, 111801. [Google Scholar] [CrossRef]
- Barak, S.; Mudgil, D.; Taneja, S. Exudate Gums: Chemistry, Properties and Food Applications—A Review. J. Sci. Food Agric. 2020, 100, 2828–2835. [Google Scholar] [CrossRef]
- Srivastava, M.; Kapoor, V.P. Seed Galactomannans: An Overview. Chem. Biodivers. 2005, 2, 295–317. [Google Scholar] [CrossRef]
- Mudgil, D.; Barak, S.; Khatkar, B.S. Guar Gum: Processing, Properties and Food Applications—A Review. J. Food Sci. Technol. 2014, 51, 409–418. [Google Scholar] [CrossRef]
- Thombare, N.; Jha, U.; Mishra, S.; Siddiqui, M.Z. Guar Gum as a Promising Starting Material for Diverse Applications: A Review. Int. J. Biol. Macromol. 2016, 88, 361–372. [Google Scholar] [CrossRef] [PubMed]
- Wang, Q.; Ellis, P.R.; Ross-Murphy, S.B. Dissolution Kinetics of Guar Gum Powders—II. Effects of Concentration and Molecular Weight. Carbohydr. Polym. 2003, 53, 75–83. [Google Scholar] [CrossRef]
- Srisuwan, Y.; Baimark, Y.; Srihanam, P. Preparation of Regenerated Silk Sericin/Silk Fibroin blend Microparticles by Emulsification Diffusion Method for Controlled Release Drug Delivery. Particul. Sci. Technol. 2017, 35, 387–392. [Google Scholar] [CrossRef]
- Wani, S.U.D.; Gautam, S.P.; Qadrie, Z.L.; Gangadharappa, H.V. Silk Fibroin as a Natural Polymeric based Biomaterial for Tissue Engineering and Drug Delivery Systems-A Review. Int. J. Biol. Macromol. 2020, 163, 2145–2161. [Google Scholar] [CrossRef]
- Meinel, L.; Hofmann, S.; Karageorgiou, V.; Kirker-Head, C.; McCool, J.; Gronowicz, G.; Zichner, L.; Langer, R.; Vunjak-Novakovic, G.; Kaplan, D.L. The Inflammatory Responses to Silk Films in vitro and in vivo. Biomaterials 2005, 26, 147–155. [Google Scholar] [CrossRef] [PubMed]
- Radulescu, D.M.; Andronescu, E.; Vasile, O.R.; Ficai, A.; Vasile, B.S. Silk Fibroin-based Scaffolds for Wound Healing Applications with Metal Oxide Nanoparticles. J. Drug Deliv. Sci. Technol. 2024, 96, 105689. [Google Scholar] [CrossRef]
- Yucel, T.; Lovett, M.L.; Kaplan, D.L. Silk-Based Biomaterials for Sustained Drug Delivery. J. Control. Release 2014, 190, 381–397. [Google Scholar] [CrossRef]
- Hofmann, S.; Stok, K.S.; Kohler, T.; Meinel, A.J.; Müller, R. Effect of Sterilization on Structural and Material Properties of 3-D Silk Fibroin Scaffolds. Acta Biomater. 2014, 10, 308–317. [Google Scholar] [CrossRef]
- Chen, Z.Y.; Wang, Y.; Zhao, Y.J. Bioinspired Conductive Cellulose Liquid-Crystal Hydrogels as Multifunctional Electrical Skins. Proc. Natl. Acad. Sci. USA 2020, 117, 18310–18316. [Google Scholar]
- Ye, J.J.; Chu, T.S.; Chu, J.L.; Gao, B.B.; He, B.F. A Versatile Approach for Enzyme Immobilization Using Chemically Modified 3D-Printed Scaffolds. ACS Sustain. Chem. Eng. 2019, 7, 18048–18054. [Google Scholar] [CrossRef]
- Song, W.T.; Das, M.; Xu, Y.D.; Si, X.H.; Zhang, Y.; Tang, Z.H.; Chen, X.S. Leveraging Biomaterials for Cancer Immunotherapy: Targeting Pattern Recognition Receptors. Mater. Today Nano 2019, 5, 100029. [Google Scholar] [CrossRef]
- Walczak-Nowicka, Ł.J.; Herbet, M. Sodium Benzoate—Harmfulness and Potential Use in Therapies for Disorders Related tothe Nervous System: A Review. Nutrients 2022, 14, 1497. [Google Scholar] [CrossRef]
- Narayana, S.; Nasrine, A.; Gulzar Ahmed, M.; Sultana, R.; Jaswanth Gowda, B.H.; Surya, S.; Almuqbil, M.; Basheeruddin Asdaq, S.M.; Alshehri, S.; Hussain, S.A. Potential Benefits of Using Chitosan and Silk Fibroin Topical Hydrogel forManaging Wound Healing and Coagulation. Saudi Pharm. J. 2023, 31, 462–471. [Google Scholar] [CrossRef] [PubMed]
- Khotsaeng, N.; Simchuer, W.; Imsombut, T.; Srihanam, P. Effect of Glycerol Concentrations on the Characteristics of Cellulose Films from Cattail (Typha angustifolia L.) Fowers. Polymers 2023, 15, 4535. [Google Scholar] [CrossRef]
- Seib, F.P. Reverse-Engineered Silk Hydrogels for Cell and Drug Delivery. Ther. Deliv. 2018, 9, 469–487. [Google Scholar] [CrossRef]
- Singh, V.; Tripathi, D.K.; Sharma, V.K.; Srivastava, D.; Kumar, U.; Poluri, K.M.; Singh, B.N.; Kumar, D. Silk Fibroin Hydrogel: A Novel Biopolymer for Sustained Release of Vancomycin Drug for Diabetic Wound Healing. J. Mol. Struct. 2023, 1286, 135548. [Google Scholar] [CrossRef]
- Fernandez-Gonzalez, A.; Gonzalez, C.d.L.; Rodríguez-Varillas, S.; Badía-Laíno, R. Bioactive Silk Fibroin Hydrogels: Unraveling the Potential for Biomedical Engineering. Int. J. Biol. Macromol. 2024, 278, 134834. [Google Scholar] [CrossRef]
- Kesharwani, P.; Bisht, A.; Alexander, A.; Dave, V.; Sharma, S. Biomedical Applications of Hydrogels in Drug Delivery System: An Update. J. Drug Deliv. Sci. Technol. 2021, 66, 102914. [Google Scholar] [CrossRef]
- Zhang, Z.; Xia, Y.; Li, X.; Zhang, Q.; Wu, Y.; Cui, C.; Liu, J.; Liu, W. Arginine-Solubilized Lipoic Acid-Induced β-Sheets of SilkFibroin-Strengthened Hydrogel for Postoperative Rehabilitation of Breast Cancer. Bioact. Mater. 2024, 40, 667–682. [Google Scholar]
- Peng, H.; Guo, W.; Wang, J.; Xia, W.; Xiong, Y.; Xu, W.; Dai, W.; Zheng, F. Synthesis, Characterization, and Therapeutic Applications of LAP/PDA Composite Nanomaterials in Silk Fibroin-Based Hydrogels for Enhanced Neuroregeneration in Stroke. Alexandria Eng. J. 2024, 91, 648–657. [Google Scholar] [CrossRef]
- Shi, Y.; Yuan, Z.; Xu, T.; Qu, R.; Yuan, J.; Cai, F.; Wang, Y.; Wang, X. An Environmentally Friendly Deproteinization and Decolorization Method for Polysaccharides of Typha angustifolia Based on a Metal Ion-Chelating Resin Adsorption. Ind. Crops Prod. 2019, 134, 160–167. [Google Scholar] [CrossRef]
- Choque-Quispe, D.; Choque-Quispe, Y.; Ligarda-Samanez, C.A.; Peralta-Guevara, D.E.; Solano-Reynoso, A.M.; Ramos-Pacheco, B.S.; Taipe-Pardo, F.; Martínez-Huamán, E.L.; Aguirre Landa, J.P.; Agreda Cerna, H.W.; et al. Effect of the Addition of Corn Husk Cellulose Nanocrystals in the Development of a Novel Edible Film. Nanomaterials 2022, 12, 3421. [Google Scholar] [CrossRef] [PubMed]
- Chen, J.-K.; Huang, H.-Y.; Tu, C.-W.; Lee, L.-T.; Jamnongkan, T.; Huang, C.-F. SI ATRP for the Surface Modifications of Optically Transparent Paper Films Made by TEMPO-Oxidized Cellulose Nanofibers. Polymers 2022, 14, 946. [Google Scholar] [CrossRef] [PubMed]
- Cao, S.; Dong, T.; Xu, G.; Wang, F. Study on Structure and Wetting Characteristic of Cattail Fibers as Natural Materials for Oil Sorption. Environ. Technol. 2016, 37, 3193. [Google Scholar] [CrossRef] [PubMed]
- Verma, D.; Sharma, S.K. Recent Advances in Guar Gum based Drug Delivery Systems and Their Administrative Routes. Int. J. Biol. Macromol. 2021, 181, 653–671. [Google Scholar] [CrossRef] [PubMed]
- Chandrika, K.S.V.P.; Singh, A.; Rathore, A.; Kumar, A. Novel Cross Linked Guar Gum-g-Poly(Acrylate) Porous Superabsorbent Hydrogels: Characterization and Swelling Behaviour in Different Environments. Carbohydr. Polym. 2016, 149, 175–185. [Google Scholar] [CrossRef]
- Gihar, S.; Kumar, D.; Kumar, P. Facile Synthesis of Novel pH-Sensitive Grafted Guar Gum for Effective Removal of Mercury (II) Ions from Aqueous Solution. Carbohydr. Polym. Technol. Appl. 2021, 2, 100110. [Google Scholar] [CrossRef]
- Mudgil, D.; Barak, S.; Khatkar, B.S. X-ray Diffraction, IR Spectroscopy and Thermal Characterization of Partially Hydrolyzed Guar Gum. Int. J. Biol. Macromol. 2012, 50, 1035–1039. [Google Scholar] [CrossRef]
- Kumar, M.; Bala, R.; Gondil, V.S.; Pandey, S.K.; Chhibber, S.; Jain, D.V.S.; Sharma, R.K.; Wangoo, N. Combating Food Pathogens Using Sodium Benzoate Functionalized Silver Nanoparticles: Synthesis, Characterization and Antimicrobial Evaluation. J. Mater. Sci. 2017, 52, 8568–8575. [Google Scholar] [CrossRef]
- Dutta, K.; Das, B.; Mondal, D.; Adhikari, A.; Rana, D.; Chattopadhyay, A.K.; Banerjee, R.; Mishrad, R.; Chattopadhyay, D. An Ex-Situ Approach to Fabricating Nanosilica Reinforced Polyacrylamide Grafted Guar Gum Nanocomposites as an Efficient Biomaterial for Transdermal Drug Delivery Application. New J. Chem. 2017, 41, 9461–9471. [Google Scholar] [CrossRef]
- Tanisood, S.; Baimark, Y.; Srihanam, P. Preparation and Characterization of Cellulose/Silk Fibroin Composites Microparticles for Drug-Controlled Release Applications. Polymers 2024, 16, 3020. [Google Scholar] [CrossRef]
- Lassoued, M.; Crispino, F.; Loranger, E. Design and Synthesis of Transparent and Flexible Nanofibrillated Cellulose Films to Replace Petroleum-Based Polymers. Carbohydr. Polym. 2021, 254, 117411. [Google Scholar] [CrossRef] [PubMed]
- Shabanpour, B.; Kazemi, M.; Ojagh, S.M.; Pourashouri, P. Bacterial Cellulose Nanofibers as Reinforce in Edible Fish Myofibrillar Protein Nanocomposite Films. Int. J. Biol. Macromol. 2018, 117, 742–751. [Google Scholar] [CrossRef]

| Samples | T660 (%) | Remaining Mass Retention Rate (%) (at 2 Days) | ||||
|---|---|---|---|---|---|---|
| PBS pH 7.4 | 1.0 M HCl | 1.0 M NaOH | 95% Ethanol | 1.0 M NaCl | ||
| SF–GG (0.2) | 65.30 ± 1.42 | 50 | 0 | 0 | 55 | 105 |
| SF–GG (0.3) | 60.22 ± 2.66 | 55 | 3 | 3 | 65 | 105 |
| SF–GG (0.4) | 51.80 ± 1.71 | 65 | 5 | 5 | 75 | 105 |
| SF–GG (0.3)–SB (0.2) | 24.80 ± 2.05 | 70 | 10 | 12 | 80 | 102 |
| SF–GG (0.3)–SB (0.3) | 10.60 ± 1.48 | 75 | 15 | 13 | 85 | 102 |
| SF–GG (0.3)–SB (0.4) | 4.50 ± 2.64 | 80 | 20 | 15 | 90 | 102 |
| Samples | WCA (°) | Figure 4 |
|---|---|---|
| SF–GG (0.2) | 21.50 | a |
| SF–GG (0.3) | 42.35 | b |
| SF–GG (0.4) | 54.05 | c |
| SF–GG (0.3)–SB (0.2) | 63.75 | d |
| SF–GG (0.3)–SB (0.3) | 70.28 | e |
| SF–GG (0.3)–SB (0.4) | 80.39 | f |
| Samples | Force at Peak (N) | Tensile Stress (MPa) | Elongation at Break (%) | Young’s Modulus (MPa) |
|---|---|---|---|---|
| SF–GG (0.2) | 150.6 | 32.9 | 24.7 | 192.4 |
| SF–GG (0.3) | 174.7 | 38.0 | 27.0 | 202.2 |
| SF–GG (0.4) | 186.1 | 40.8 | 18.5 | 215.8 |
| SF–GG (0.3)–SB (0.2) | 205.7 | 46.4 | 12.3 | 219.7 |
| SF–GG (0.3)–SB (0.3) | 207.4 | 48.1 | 10.8 | 221.5 |
| SF–GG (0.3)–SB (0.4) | 215.5 | 53.3 | 8.4 | 226.3 |
| Hydrogels | Onset of Decomposition (°C) | Td,max (°C) | Charred Residue Weight at 800 °C (%) |
|---|---|---|---|
| SF film | 95 | 323 | 22 |
| GG film | 90 | 227, 311 | 20 |
| SB powder | - | 553 | 22 |
| SF–GG (0.3) | 90 | 152, 300, 375 | 22 |
| SF–GG (0.3)–SB (0.3) | 90 | 154, 375, 531 | 22 |
Disclaimer/Publisher’s Note: The statements, opinions and data contained in all publications are solely those of the individual author(s) and contributor(s) and not of MDPI and/or the editor(s). MDPI and/or the editor(s) disclaim responsibility for any injury to people or property resulting from any ideas, methods, instructions or products referred to in the content. |
© 2025 by the authors. Licensee MDPI, Basel, Switzerland. This article is an open access article distributed under the terms and conditions of the Creative Commons Attribution (CC BY) license (https://creativecommons.org/licenses/by/4.0/).
Share and Cite
Thonpho, A.; Baimark, Y.; Tanisood, S.; Srihanam, P. Effects of Guar Gum and Sodium Benzoate on the Properties and Hydrophilicity of Silk Fibroin Hydrogels. Polymers 2025, 17, 425. https://doi.org/10.3390/polym17030425
Thonpho A, Baimark Y, Tanisood S, Srihanam P. Effects of Guar Gum and Sodium Benzoate on the Properties and Hydrophilicity of Silk Fibroin Hydrogels. Polymers. 2025; 17(3):425. https://doi.org/10.3390/polym17030425
Chicago/Turabian StyleThonpho, Ansaya, Yodthong Baimark, Suchai Tanisood, and Prasong Srihanam. 2025. "Effects of Guar Gum and Sodium Benzoate on the Properties and Hydrophilicity of Silk Fibroin Hydrogels" Polymers 17, no. 3: 425. https://doi.org/10.3390/polym17030425
APA StyleThonpho, A., Baimark, Y., Tanisood, S., & Srihanam, P. (2025). Effects of Guar Gum and Sodium Benzoate on the Properties and Hydrophilicity of Silk Fibroin Hydrogels. Polymers, 17(3), 425. https://doi.org/10.3390/polym17030425








